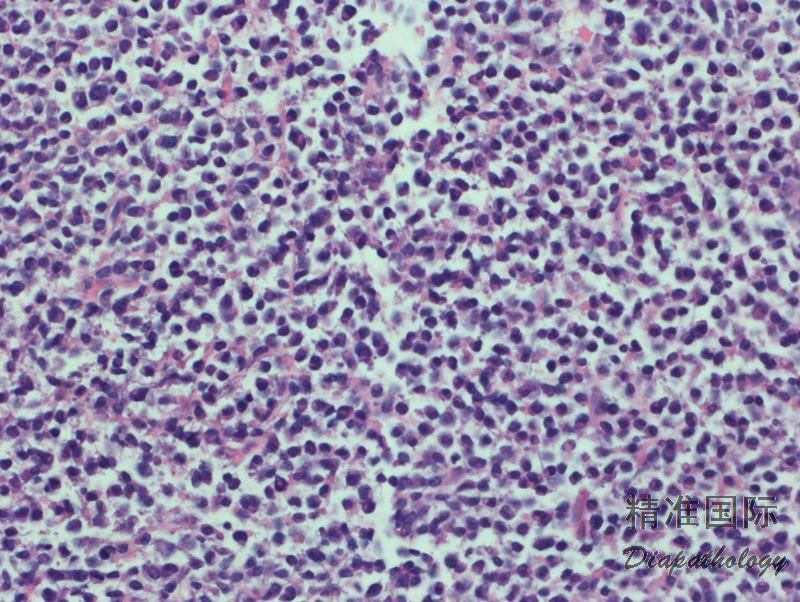

淋巴浆细胞淋巴瘤
Lymphoplasmacytic Lymphoma
概述:
LPL 系成熟小 B 淋巴细胞肿瘤并伴不同程度的浆细胞分化,形成由小淋巴细胞,浆样淋巴细胞和浆细胞组成的谱系,不符合其它小 B 细胞淋巴瘤伴浆细胞分化的诊断标准。LPL 常有克隆性球蛋白增高(一般为 IgM),绝大多数病例(>90%)有 MYD88 L265P 突变,但这些都不是诊断所必需的。 Waldenstrom Macroglobulinemia (WM) 见于相当一部分 LPL 病例,但不等同于 LPL,其临床定义为 LPL 患者累及骨髓伴任何程度的克隆性球蛋白增高。
发病部位: 骨髓为原发部位,常累及淋巴结和结外部位。
诊断要点:
- 发病年龄为 60-70 岁,男性较多。骨髓受侵,淋巴结和脾脏可肿大。常表现为贫血和血小板减少及相关症状,还可有全身症状如体重减轻、盗汗。克隆性球蛋白增高导致的高黏稠血症可引起疲劳、精神状态变化以及视觉障碍,其沉积可导致周围神经病变和肾功能损害。
- 外周血可见循环肿瘤细胞和红细胞成钱串样重叠;骨髓几乎总是受侵犯,非小梁旁或小梁旁, 间质或弥漫侵润;淋巴结受侵以副皮质区为明显,可累及整个淋巴结。肿瘤细胞由小淋巴细胞、浆淋巴细胞和浆细胞谱系组成,可见 Dutcher 或 Russell 小体。肥大细胞数增加。
- 免疫组化和流式细胞 CD20 等 B 细胞抗原阳性,轻链染色或原位杂交揭示单克隆浆淋巴细胞或浆细胞。
- 血浆单克隆免疫球蛋白(IgM)增高。
- MYD88 突变率 > 90%,6q 缺失也常见;CXCR4 突变率 30%。
- IGH @基因重排。

分子标记:
MYD88 突变率 > 90%,6q 缺失也常见;CXCR4 突变率 30%
鉴别诊断:
- 边缘区淋巴瘤(MZL)(淋巴结边缘区淋巴瘤,MALT 淋巴瘤,SMZL) :细胞有边缘区分化倾向,或呈现单核细胞样形态,SMZL 在外周血可见绒毛样细胞,在骨髓常见特征性窦侵润。 没有克隆性 IgM 副蛋白的明显增高。MYD88 无突变。MALT 淋巴瘤常见染色体基因易位有:API2-MALT1,IGH-MALT1,BCL10-IGH;SMZL 则常见 7q 缺失。
- CLL 伴浆细胞分化 :弱表达 CD20 和轻链并共表达 CD5 和 CD23 有助鉴别。无 MYD88 突变。
- 意义不明的 IgM 单克隆球蛋白血症 :部分病例有 MYD88 突变,但血清 IgM 浓度低,骨髓中克隆性浆细胞少于 10%,无器官损害和临床症状,可进展为淋巴浆细胞淋巴瘤或其它 B 细胞淋巴瘤。
- IgG4 相关硬化性病 :病变组织 IgG4+ 浆细胞增高,无克隆浆细胞。血肿 IgG4 浓度增高。
预后:
中位生存期 5 年。严重贫血,血小板减少,显著高黏稠血症,或有全身症状患者预后不良。 6q 和 TP53 缺失预后不佳。少数病例可转化为弥漫大 B 细胞淋巴瘤,生存率差。
治疗:
临床观察随访(无症状患者),化疗,血浆置换,脾切除,干细胞移植。
